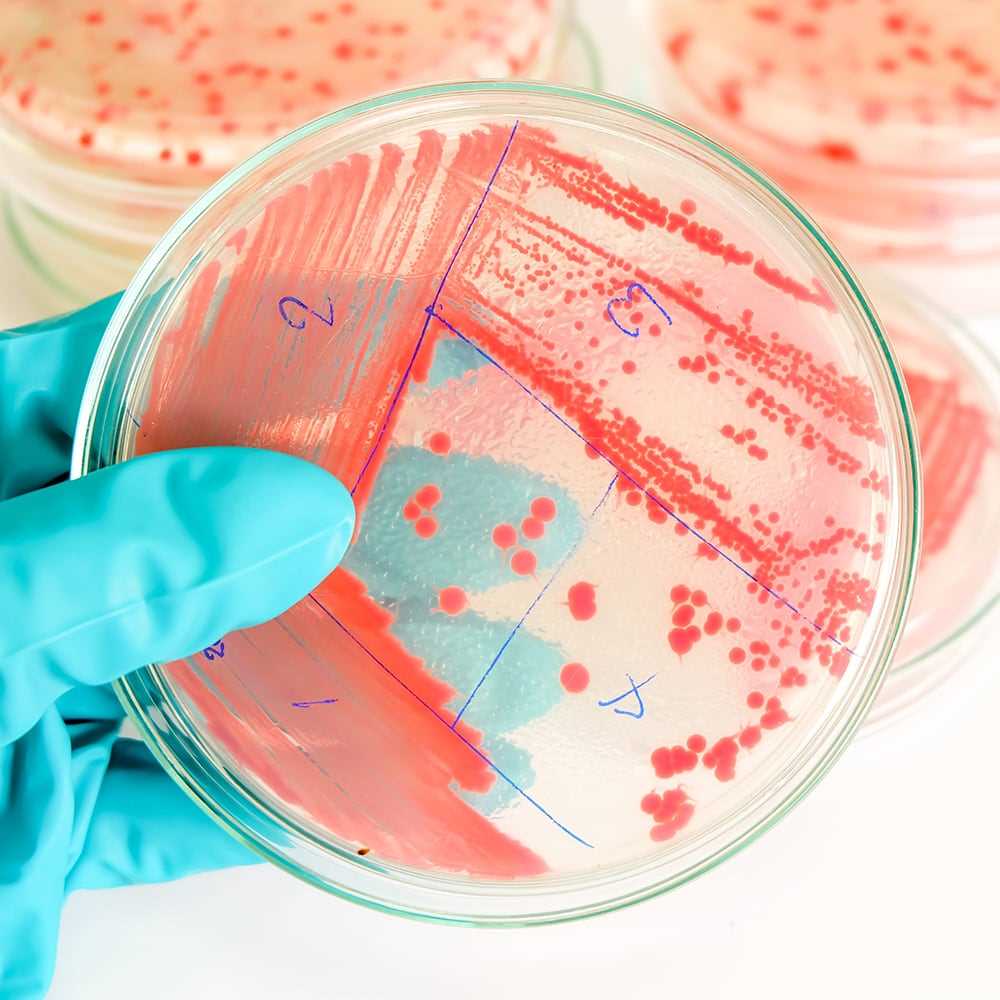
Microbiologia

-
 Search
Search -
 español
español
-
 Login
Login
ALS Solutions
ALS Solutions provides you with online access to your sample and analytical information from anywhere.
LoginGeochemistry WebtrieveTM
Retrieve results and track sample progress in real time with access to featured digital products such as CoreViewer™ and ALS QCPro™.
Login
Tribology 360
This convenient application lets customers closely track oil analysis reports in process in real time.
Login